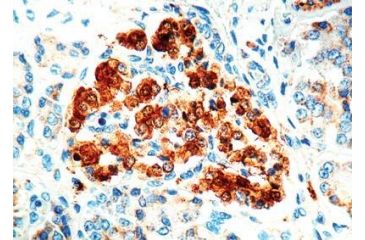
Image of Diagnostic Biosystems Nse Rtu Polyclonal Ab PDR 006

Tap Tap to Zoom
Code: YW-VW-PDR-006
MPN: PDR 006
Product Info for Diagnostic Biosystems Nse Rtu Polyclonal Ab PDR 006
Diagnostic Biosystems Nse Rtu Polyclonal Ab PDR 006 is one of the many quality laboratory and scientific products we have to offer at very competitive pricing. Diagnostic Biosystems Nse Rtu Polyclonal Ab PDR 006 / 99991-052 is part of a wide selection of Diagnostic Biosystems Antibodies. Combining excellent quality with an affordable price, the Diagnostic Biosystems Nse Rtu Polyclonal Ab PDR 006 / 99991-052 can meet your scientific research needs while still offering a good value for a budget conscious end user. If you have any questions about any of our Antibodies please do not hesitate to contact our customer service for further guidance.![]()
NSE. Rabbit, This antibody reacts with gamma-gamma isoenzymes in neurons of brain, in the Langerhans islets of the pancreas and in peripheral nerves of the skin. .
Specifications for Diagnostic Biosystems Nse Rtu Polyclonal Ab PDR 006:
| Description: | NSE RTU POLYCLONAL AB |
| Unit: | Each (6 ML) |